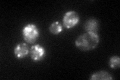
YMR071C

View description
Integral membrane protein localized to late Golgi vesicles along with the v-SNARE Tlg2p; may interact with ribosomes, based on co-purification experiments
Localization:
Intensity:
Fold change:
Significance:
-
C’ GFP library in SD

punctate58.17 -
N' NOP1pr-GFP in SD

punctate121.915 -
N' TEF2pr-mCherry in SD

cell periphery,vacuole271.111 -
N' NATIVEpr-GFP in SD

punctate41.4739 -
N' TEF2pr-VC and Cyto-VN in SD

punctate46.9782 -
C’ GFP library in SD+DTT

punctate70.181.2No -
C’ GFP library in SD+H2O2

punctate61.851.06Yes -
C’ GFP library in Starvation Media
punctate92.391.58Yes -
C’ GFP library on the background of Pup2-DaMP

punctate -
C’ GFP library on the background of CCT mutant

punctate52.73230.906335No
